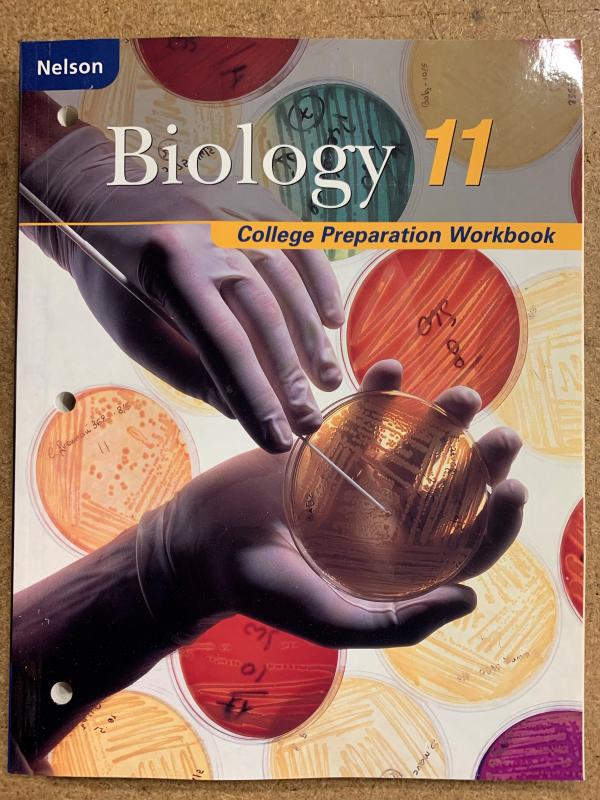
Nelson Biology 11 College Prep Workbook

If you can’t find what you are looking for, our friendly staff are ready to help!
Western Campus Resources guarantees every book we sell. If the condition of a book you receive does not meet your expectations, please contact us and we will either replace the book or grant a full refund.
Login or register to see pricing and availability
Nelson Biology 11 is a one-of-a-kind hybrid resource that integrates the best features from both Applied and University Preparation resources to ensure success in college preparation courses. Features & Benefits: ? Workbooks help students manage their learning and ultimately stimulate better performance ? Average of 2-3 pages of support material per text section which include organizational supports, Alternative Exercises, and Extension Exercises ? Strong support for reading/comprehension, work habits, and study/organizational skills